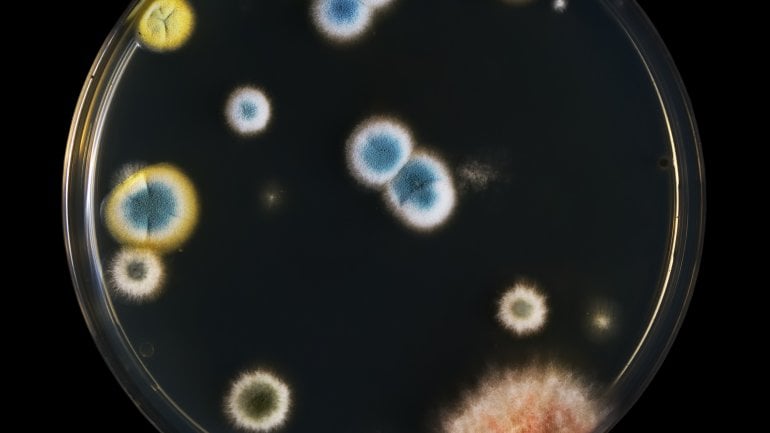

Pilze (Fungi)
Das Reich der Pilze (Fungi) ist sehr umfangreich: Es besteht aus etwa einer Millionen Arten. Pilze machen über ein Drittel (ca. 40%) der Biomasse der Erde aus. Sie kommen überall auf der Welt vor und sind auch an extremen Standorten wie dem antarktischen Eis oder in der Wüste auf Steinflächen zu finden.
Allgemeines
Im Vergleich zu der recht großen Artenzahl des Pilzreiches haben nur relativ wenige Pilz-Arten letztlich eine Bedeutung für die Gesundheit des Menschen: Rund 50 Arten können beim Menschen Pilzerkrankungen (sog. Mykosen) wie Hautpilz (z.B. Fußpilz) und Nagelpilz auslösen. Circa 300 weitere Arten können problematisch für Menschen mit stark geschwächtem Immunsystem sein.
Seit Beginn des 20. Jahrhunderts nutzt man Pilze auch für medizinische Zwecke, zum Beispiel zur Herstellung von Antibiotika wie Penicillin. Pilze spielen außerdem in vielen Bereichen der Lebensmittelindustrie eine wichtige Rolle, unter anderem:
- als Speisepilze
- bei der alkoholischen Gärung
- bei der Käseherstellung
- für Sauerteig
- bei manchen ostasiatischen Lebensmittel (wie z.B. Sojasoße, Koji, Sufu, Tempeh)
Biotechnologisch kommen Pilze beispielsweise in diesen Bereichen zum Einsatz:
- bei der Klärung von Obst- und Gemüsesäften
- bei der Produktion von Vitaminen
- als Biosensoren in Kläranlagen
- in der Pharmakaherstellung
Die meisten Pilze sind mikroskopisch klein und ohne Hilfsmittel für das menschliche Auge unsichtbar. Bei Großpilzen wie zum Beispiel den Waldpilzen sieht man im Grunde nur den Fruchtkörper, während sich unterirdisch der eigentliche und größere Anteil des Pilzes befindet.
Pilze bilden neben Tieren und Pflanzen ein eigenständiges Reich. Aufgrund ihrer genetischen und physiologischen Eigenschaften stehen sie jedoch den Tieren verwandtschaftlich wesentlich näher als den Pflanzen.
Einteilung
Aus biologischer Sicht kann man die Pilze (Fungi) in fünf Abteilungen unterteilen:
- Töpfchenpilze (Chytridiomycota): meist einzellige Pilze, die als sehr ursprüngliche Form angesehen werden
- Jochpilze (Zygomycota): bilden jochartige Brücken zwischen den Hyphen während der sexuellen Fortpflanzung
- Arbuskuläre Mykorrhizapilze (Glomeromycota): bilden über Membranausstülpungen symbiotische Beziehungen zu Pflanzen
- Schlauchpilze (Ascomycota): bilden Sporen in charakteristischen Schläuchen (Asci); einige Arten bilden mit dem Auge erkennbare Fruchtkörper und zählen daher zu den Großpilzen
- Basidienpilze (Basidiomycota): die überwiegende Anzahl von Großpilzen gehören zu dieser Gruppe, die Sporen in Basidien bildet
Morphologie
Die Größe der Pilze (Fungi) reicht von mikroskopisch kleinen Arten bis zu den leicht erkennbaren Großpilzen. Pilze existieren aus miteinander kommunizierenden Röhren, die aus langgestreckten Zellen bestehen (Hyphengeflecht) oder in Form von Einzellern als Hefen oder Sprosspilze.
Hyphen (Pilzfäden) haben ein fädiges, manchmal verzweigtes Aussehen und bilden ein Geflecht, das Myzel genannt wird. Sie bestehen aus einzelnen, aneinander gereihten röhrenförmigen Zellen, die durch Trennwände (Septen) strukturiert sind. Diese Trennwände besitzen Poren, durch die ein Austausch von Zellflüssigkeit möglich ist.
Hefezellen oder Sprosszellen sind rund oder oval. Sie liegen normalerweise einzeln vor, nur gelegentlich bilden sie Ketten. Da diese den Hyphen auf den ersten Blick sehr ähneln, nennt man sie auch Pseudohyphen.
Existieren Pilze nur in Hyphenform, spricht man von einem Dauermyzel. Wechseln sie dagegen ihren Zustand zwischen Myzel- und Hefephase, nennt man dieses Verhalten Dimorphismus.
Vermehrung
Pilze (Fungi) können sich sowohl ungeschlechtlich (asexuell) als auch geschlechtlich (sexuell) vermehren.
Ungeschlechtliche (asexuelle) Vermehrung
Bei Pilzen ist eine ungeschlechtliche (asexuell, vegetative) Vermehrung sehr häufig. Die Vermehrung erfolgt hierbei nicht durch die Ausbildung von Geschlechtszellen, sondern durch die Entstehung verschiedener Typen von Sporen:
- Konidiosporen: Durch Abschnürung an der Spitze bestimmter Pilz-Hyphen bilden sich so genannte Konidiophoren, aus denen später die Konidiosporen freigesetzt werden.
- Sporangiosporen: In besonderen Hyphen, den Sporangiophoren, bilden sich sackartige Fruchtbehälter, in deren Inneren die Sporangiosporen entstehen
- Arthrosporen: Arthrosporen entstehen durch das Zerbrechen von Hyphen in Einzelzellen.
- Chlamydosporen: Chlamydosporen entwickeln sich sowohl innerhalb der Hyphen als auch durch sogenannte Sprossung.
Geschlechtliche (sexuelle) Vermehrung
Bei der geschlechtlichen (sexuellen) Vermehrung bilden die Pilze zunächst Geschlechtszellen, sogenannte Gameten. Diese entstehen durch die Reduktions- oder Reifeteilung (Meiose) und enthalten einen einfachen (haploiden) Chromosomensatz.
Bei der Verschmelzung zweier Gameten bildet sich wieder eine Zelle mit einem doppelten (diploiden) Chromosomensatz. Diese nennt man Zygote oder sexuelle Spore. Bei der geschlechtlichen Vermehrung kommt es zu einer Neukombination des elterlichen Erbguts.
Pilze als Krankheitserreger
Zum Reich der Pilze (Fungi) gehören etwa 150.000 Arten, von denen einige natürliche Bestandteil der normalen Flora des Menschen sind. Diese sogenannten Kommensalen leben zwar als Parasiten auf oder in ihrem Wirt, schädigen ihn aber nicht.
Wird das Gleichgewicht zwischen Wirt und Kommensale gestört, kann es zu einer Erkrankung kommen. Meist wird dieses Ungleichgewicht durch eine andere Erkrankung verursacht, die das Immunsystem schwächt. Eine solche Infektion wird als endogen (von innen verursacht) bezeichnet.
Pilze, die nicht Bestandteil der Normalflora sind und von außen eindringen, verursachen eine exogene Infektion. Erkrankungen durch Pilze nennt man Mykosen.
Für humanmedizinische Zwecke ist eine biologische Klassifizierung der Pilze von untergeordneter Bedeutung. Eine wichtigere Rolle spielt stattdessen die Art der Erkrankung:
- Primäre Mykosen, Systemmykosen: Bei diesen Pilzerkrankungen werden die Pilze über die Atemluft aufgenommen und vermehren sich in der Lunge, wo sie Lungenmykosen hervorrufen. Von der Lunge aus können sich die Pilze übers Blut oder das Lymphsystem in andere Organe einschließlich der Haut gelangen und dort Infektionsherde auslösen.
- Kutane Mykosen: Die Pilze dieser Erkrankungen können jene Gewebe infizieren, in denen viel Keratin vorkommt, also Haut, Haare oder Nägel. Sie heißen deshalb auch Dermatophyten, was so viel bedeutet wie "auf der Haut wachsend".
- Subkutane Mykosen: Die Pilze dieser Mykosen leben eigentlich im Boden oder auf absterbenden Pflanzen. Sie können aber durch kleine Verletzungen der Haut in den Körper bzw. ins unter der Haut liegende (subkutane) Bindegewebe eindringen. Dort siedeln sie und können sich weiter im Körper ausbreiten.
- Opportunistische Mykosen: Diese Pilzerkrankungen betreffen vor allem die Haut und die Schleimhäute. Eine Erkrankung entsteht dann, wenn bereits geschwächte Abwehrkräfte vorliegen. Opportunistische Mykosen gehören zu den endogenen Infektionen. Eine Erkrankung, die zu den opportunistischen Mykosen zählt, ist zum Beispiel die Candida-Infektion (Soor) oder die Aspergillose.
Beispiele für krankheitserregende Pilze sind Candida albicans, Aspergillus-Arten, Cryptococcus neoformans, Coccidioides immitis und Histoplasma capsulatum.